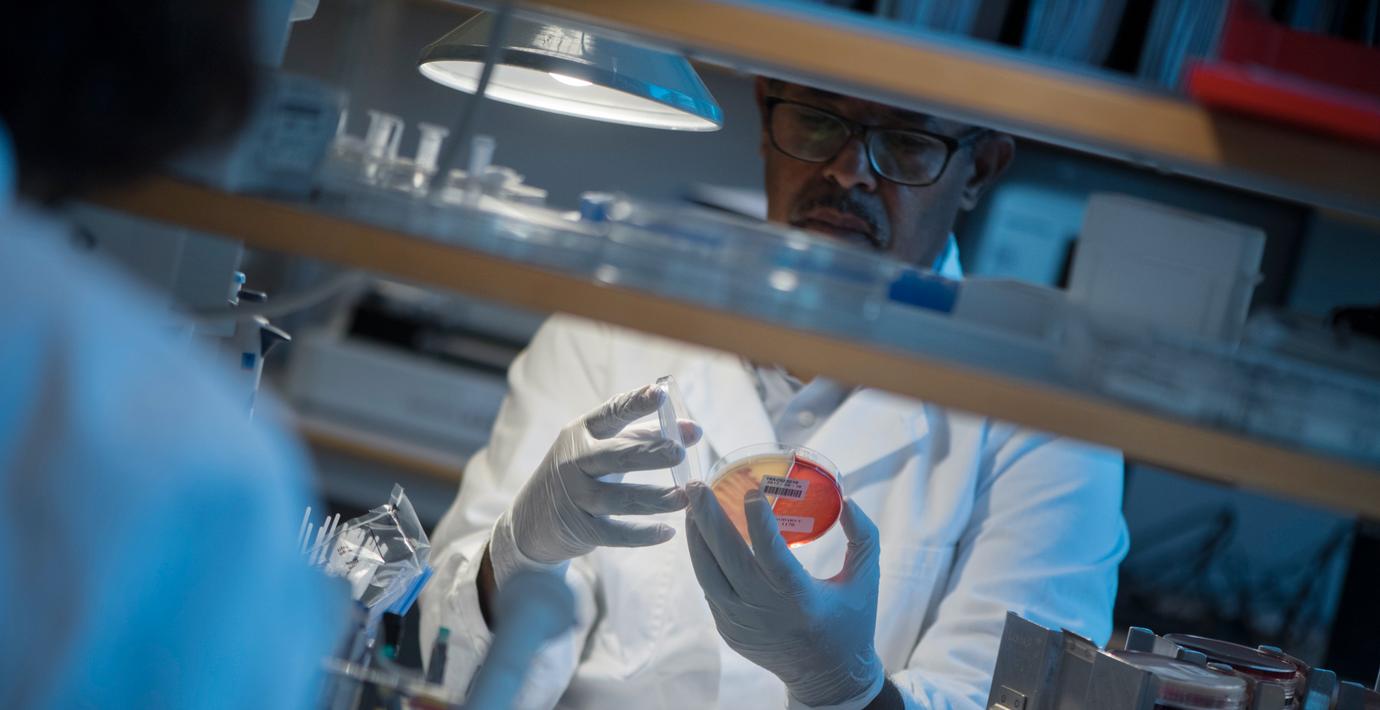

Nya siffror: Över 100 har dött i covid-19 i Sverige
Totalt 102 personer i Sverige har avlidit efter att ha smittats av covid-19, visar Folkhälsomyndighetens senaste uppdatering.
Det är en ökning med tio personer det senaste dygnet. Totalt har 3 447 personer i Sverige bekräftats smittade. Mörkertalet tros dock vara stort.
Läs mer
Omni är politiskt obundna och oberoende. Vi strävar efter att ge fler perspektiv på nyheterna. Har du frågor eller synpunkter kring vår rapportering? Kontakta redaktionen



